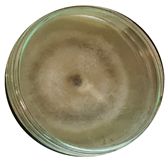
Microorganisms 11 00707 i002 Microorganisms 11 00707 i002
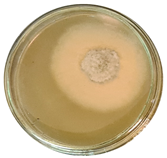
Microorganisms 11 00707 i004 Microorganisms 11 00707 i004
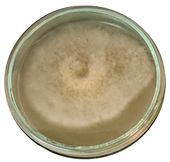
Microorganisms 11 00707 i009 Microorganisms 11 00707 i009
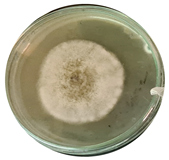
Microorganisms 11 00707 i011 Microorganisms 11 00707 i011
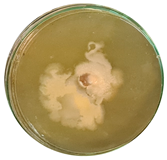
Microorganisms 11 00707 i012 Microorganisms 11 00707 i012

Abstract
Fungal diseases caused by Alternaria alternata constitute a significant threat to the production and quality of a wide range of crops, including beans, fruits, vegetables, and grains. Traditional methods for controlling these diseases involve synthetic chemical pesticides, which can negatively impact the environment and human health. Biosurfactants are natural, biodegradable secondary metabolites of microorganisms that have also been shown to possibly have antifungal activity against plant pathogenic fungi, including A. alternata being sustainable alternatives to synthetic pesticides. In this study, we investigated the potential of biosurfactants of three bacilli (Bacillus licheniformis DSM13, Bacillus subtilis DSM10, and Geobacillus stearothermophilus DSM2313) as a biocontrol agent against A. alternata on beans as a model organism. For this fermentation, we describe using an in-line biomass sensor monitoring both permittivity and conductivity, which are expected to correlate with cell concentration and products, respectively. After the fermentation of biosurfactants, we first characterised the properties of the biosurfactant, including their product yield, surface tension decrement capability, and emulsification index. Then, we evaluated the antifungal properties of the crude biosurfactant extracts against A. alternata, both in vitro and in vivo, by analysing various plant growth and health parameters. Our results showed that bacterial biosurfactants effectively inhibited the growth and reproduction of A. alternata in vitro and in vivo. B. licheniformis manufactured the highest amount of biosurfactant (1.37 g/L) and demonstrated the fastest growth rate, while G. stearothermophilus produced the least amount (1.28 g/L). The correlation study showed a strong positive relationship between viable cell density VCD and OD600, as well as a similarly good positive relationship between conductivity and pH. The poisoned food approach in vitro demonstrated that all three strains suppressed mycelial development by 70–80% when applied with the highest tested dosage of 30%. Regarding in vivo investigations, B. subtilis post-infection treatment decreased the disease severity to 30%, whereas B. licheniformis and G. stearothermophilus post-infection treatment reduced disease severity by 25% and 5%, respectively. The study also revealed that the plant’s total height, root length, and stem length were unaffected by the treatment or the infection.
1. Introduction
In recent decades, the toxicity of chemically synthesised fungicides has become an increasing problem, so technologies that offer more sustainable, environmentally friendly solutions have come to the fore in all areas of industry [1]. Surfactants are molecules that can reduce surface tension and are used in various applications, including cleaning products, detergents, cosmetics, and agriculture. Synthetic surfactants have traditionally been used for these purposes, but there has been a growing interest in using surfactants produced by living organisms, particularly microorganisms, as a sustainable alternative. Biosurfactants have several advantages over synthetic surfactants, including being less toxic to the environment and health, biodegradability, and using renewable raw materials [2,3]. They have also been shown to possess antimicrobial activity, making them potential candidates for use in medicine and agriculture. However, the high production costs of biosurfactants have limited their widespread use [4].
Several research efforts are being conducted to identify novel bioprotective and antibacterial chemicals for technological and medical uses and for treatment-resistant diseases. However, it is difficult to determine the types of secondary metabolites a microorganism produces due to a lack of understanding of the molecular mechanisms underlying their production. Primary approaches often involve a variety of cultivation conditions and experimental assays before determining the types of secondary metabolites produced by a microorganism [5,6].
The increasing incidence of fungal infections is a rising health and economic problem for plants, people, and animals. Alternaria alternata is one of the most frequent pathogenic fungi owing to its vast host range and capacity to produce severe infections in plants and animals [7,8,9]. This fungus is known to cause leaf spots, fruit rot, and stem canker in crops, such as apples, tomatoes, and pepper. In addition, it has been reported as a causative agent of allergic bronchopulmonary mycosis in immunocompromised individuals [10,11,12].
Monitoring microorganism concentration during bacterial fermentations is one of the critical tasks and challenges of bioprocesses. Traditional methods involve taking and analysing samples off-line, which can be time-consuming and provide only discrete data points [12,13,14]. Standard techniques for detecting cell density during fermentation, such as optical density, turbidity, and dry cell weight, are often used to determine the total number of cells in a sample. However, the dilution plate (CFU-colony forming unit) and most probable number (MPN) techniques are routinely used for more exact counts of living cells. These methods are believed to be more accurate, although they are more labour-intensive and time-consuming than conventional processes. In-line sensors can provide nearly continuous measurements, which are helpful in process analytical technology (PAT) and quality by design (QbD) principles [15,16,17]. Capacitance methods are fast, capable of in-line measurement providing living cell numbers, and less sensitive to external influences. The Incyte capacitance sensor by Hamilton (Bonaduz, Switzerland) measures permittivity at several frequencies, resulting in a permittivity profile vs. frequency called dielectric spectroscopy; this allows for the almost continuous determination of living cell numbers [18]. At the same time, it also follows the conductivity, which may correlate to the pH changes in the broth mainly caused by primary metabolites.
Recent studies have shown that a biosurfactant extract produced from a Bacillus strain had significant antifungal action against A. alternata [19]. The extract inhibited the development of the fungus and reduced the severity of leaf spot symptoms in apple plants. In addition, the extract was non-toxic to plant cells and had no detrimental impact on plant growth and development. This study demonstrates the possibility of employing biosurfactant extracts from Bacillus spp. as a natural and efficient management method against pathogenic A. alternanta plant fungal infections [20,21,22,23].
The present study aims to produce and characterise biosurfactants from Bacillus subtilis, Bacillus licheniformis, and Geobacillus stearothermophilus and to investigate the antifungal properties of their biosurfactants against A. alternata in vitro and in vivo. For those purposes, we examined numerous plant development and health metrics to estimate the agricultural plant-protecting potential of these biosurfactants. By completing these investigations, we intend to add to the expanding body of knowledge about biosurfactants’ production and possible uses in sustainable agriculture.
2. Materials and Methods
2.1. Bacteria
The Bacillus spp. used in this study were Geobacillus stearothermophilus DSM2313 purchased from Leibniz Institute DSMZ-German Collection of Microorganisms and Cell Cultures GmbH, Bacillus subtilis DSM10, and Bacillus licheniformis DSM13 acquired from the National Collection of Agricultural and Industrial Microorganism (NCAIM, Budapest, Hungary) under the identification number of, B.02624T and B.02069T, respectively. To maintain strains, they were stored at 4 °C on Luria–Bertani (LB) agar plates (10.0 g/L tryptone, 5.0 g/L yeast extract, 10 g/L NaCl, 15.0 g/L agar).
2.2. Pathogenic Fungi
The pathogenic fungi used in the experiments were Alternaria alternata F.00969 purchased from NCAIM.
2.3. Fermentation
The fermentation was carried out in Biostat Q (B. Braun, Melsungen, Germany) bench-top fermenters with magnetic stirrers (300 rpm) temperature control, pH and oxygen electrodes (Mettler, Switzerland) additionally including a Hamilton Incyte living cell sensor and equipped with a cyclone for separating foams from the air outlet. For the biosurfactant fermentation, a minimal medium was used; 1 litre of minimal media contained 34.0 g glucose (Hungrana Kft., Szabadegyháza, Hungary), 6.0 g KH2PO4, 2.7 g Na2HPO4, 1.0 g NH4NO3, 0.1 g MgSO4 * ·7H2O, 1.2 × 10−3 g CaCl2, 1.65 × 10−3 g FeSO4*7H2O, 1.5 × 10−3 g MnSO4*4H2O and 2.2 × 10−3 g Na-EDTA [24,25]. In this investigation, the cell density in the culture was measured using the Hamilton Incyte in-line viable cell density (VCD) monitoring system. The conductivity signal of the Incyte sensor was discovered to be associated with pH. In the case of Geobacillus, conductivity also correlated to the product amount making possible real-time product measurements [13]. The system is comprised of three components: Incyte viable cell density unit DN12 capacitance sensor, a pre-amp signal transmitter, and a biomass controller, and all these parts are manufactured by Hamilton in Bonaduz, Switzerland.
2.4. Isolation of Biosurfactant
First, cells were removed from the fermented broth by centrifuging at 4000 rpm for 20 min with Janetzki K23D (MLW, GDR) set to 4 °C. The biosurfactants were then recovered using acid precipitation from the clear supernatant. The pH of the supernatant was set to 2 using 6 M HCl, and the temperature was maintained at 4 °C overnight. This precipitated the biosurfactants out of the solution, which was then centrifuged at 4000 rpm for 20 min to separate the biosurfactant-containing precipitate from the supernatant. The supernatant was dumped out, and the residue was resuspended. Using NaOH, the pH of the resuspended material was adjusted to 7. After pipetting the suspension into pre-weighed vials, it was lyophilised (Alpha 2-4, Martin Christ, Germany). We can determine the dry mass of the sample by calculating the difference between these two values, which provides us with the mass of the biosurfactant left after lyophilization [26,27,28].
2.5. Antifungal Assay
Biosurfactant’s antifungal activities were in vitro investigated utilising the poisoned food technique. Mixing 39 g of potato dextrose agar (PDA) powder with 1 litre of distilled water was followed by boiling, mixing, and autoclaving for 15 min until homogenous. After semi-cooling, various concentrations (0, 5, 10, 20, and 30%) of cell-free fermentation broth supernatant (1 mL/plate) containing biosurfactant were gently mixed with 25 mL PDA and put in a sterile petri dish before being further cooled. After solidification, a sterilised cork borer was transferred to a 6 mm agar disk from A. alternata culture grown for 7 days onto each culture plate. The cultures were incubated for an additional week at 25 °C. The diameter of the fungal colony was determined, and the inhibition percentage of the mycelial growth of the test fungus by the biosurfactant was calculated using the following formula [29].
where
- dc represents the diameter of the fungal colony in the control group (without biosurfactant), and
- dt represents the diameter of the fungal colony in the treatment group (with the biosurfactant).
2.6. Planting, Transplanting, Growing, and Treating Plants
The planting of pinto beans (Phaseolus vulgaris) in 48 planting trays was performed with BIORG MIX potting soil. The soil was regularly watered and then covered with a transparent covering to minimise moisture loss. After one week, the seedlings were transferred into pots in triplicate, resulting in 10 groups of 3 plants each (30 plants in total). The plants were stored in an ozone-sterilised (UV-C lamp 2.5 W/2 m2, Anco Electrics Ltd.,Budapest, Hungary) 900 × 900 × 780 mm container. The plants were exposed to 3700 lux of light for 14 h daily at 25 degrees Celsius. The vegetation was watered three times each week. Using a spray bottle, infections and treatments were administered outside the box. The box was divided into two compartments by a transparent plexi sheet, one for control (not infected) and the other for fungal-infected plants. Plants without fungal infection consisted of nontreated (control) and bacterial broth treated ones (BS-0, GS-0, BL-0). A. alternata spores infected plants were divided into two groups, bacterial broth treatment before fungal infections (BS-A, GS-A, BL-A) and treatment after infection (A-BS, A-GS, A-BL) as indicated in Table 1. Thus, we could test the efficacy of both preventive (pre-infection treatment) and therapy (post-infection treatment) applications. Bacterial broth for treatment was made by fermenting bacilli for four days, centrifuging them, and the supernatant was sprayed onto plant leaves.
Table 1.
Configurations of plant treatments.
2.7. Disease Incidence and Severity
The disease severity index (DSI%) formula is a mathematical calculation that measures the severity of a disease in a particular population or sample. It is often used in plant pathology. The experiment was stopped at week eight after transplanting from the nursery. The incidence and severity of Alternaria infection on the leaves of the plants were determined according to the following classification shown in Table 2 [30].
Table 2.
Score for disease severity rating given to the plant leaves.
Leaves with a value other than 0 were considered infected; the number of infected leaves divided by the total number of leaves was calculated as the incidence:
The severity of the infection was calculated using the following formula:
where
n0–n5 is the number of leaves in corresponding categories.
2.8. Chlorophyll Concentration of Leaves
The chlorophyll content of leaves was measured using a spectrophotometer. Each plant had a leaf of comparable size cut, weighed on an analytical scale, and then crushed with acetone to extract pigments. The pigments were then separated from the solvent by centrifuging the acetone solution in 15 mL Falcon tubes at 4000 rpm for 10 min. At two distinct wavelengths (=663, 645 nm) [31], the absorbance of the supernatant was determined using a spectrophotometer. Three repetitions of the measurement were performed using glass cuvettes.
Using the following formulas, the chlorophyll a and b concentrations in the leaf were calculated:
where
A663 is the absorbance of the solution measured at λ = 663 nm (-),
A645 is the absorbance of the solution measured at λ = 645 nm (-),
V is the volume of the solution (mL), and
W is the weight of the leaf (g).
2.9. Data Analysis
In this study, the means of the three treatments were compared using the Tukey test on all measurements. The statistical analysis was conducted utilising the IBM SPSS Statistics 26.0 software package (IBM Corp., Chicago, IL, USA) for data evaluation and analysis. To determine statistical significance, the significance level for all statistical tests was set to p < 0.05.
3. Results
3.1. Fermentation
Figure 1 introduces the time course of the fermentation. The usefulness of the in-line sensor is evident since the significant cell growth occurred in samplings gaps, i.e., during the night. All bacteria reached an OD600 value between 2.5–3, while 1.1–1.3 g/L could be reached regarding product amounts. B. licheniformis was found as most productive since it reached a plateau in 10 h compared to the other two bacteria around 20 h. The time courses also demonstrate the correlations of permittivity-based VCD measurements to off-line determined OD600 values and conductivity to pH values.

Figure 1.
Time course of biosurfactant fermentations: (A) B. licheniformis ▬ In-line detected total products IDTP (=0.65 × conductivity [mS/cm] + 0.1); (B) B. subtilis ▬ IDTP (=0.65× conductivity [mS/cm] + 0.1); (C) G. stearothermophilus ▬ IDTP (=0.65* conductivity [mS/cm] + 0.1) biosurfactant fermentation, ▬ pH, ▬ VCD (=10× permittivity [mS/cm] + 1.8), ◊ OD600 and ■ product.
Verification of In-Line Sensor Usefulness
Correlations are more exactly presented in Figure 2, where VCD is plotted versus OD600, resulting in correlation coefficients between 0.6 and 0.92, where the lowest value belongs to B. subtilis. The lack of off-line determined middle-range data for those bacteria because of the night period causes a bit higher uncertainty besides an acceptable correlation coefficient.
Figure 2.
Correlation curve for VCD and OD600.
Figure 2 depicts that the correlation between VCD and OD600 has a substantial positive link, especially for B. licheniformis and G. stearothermophilus, with an R2 of 0.9262 and 0.9202, respectively. This indicated that as permittivity rises, so does OD600.
In Figure 3, the correlation between conductivity and pH with an R2 value of 0.9043, 0.889, and 0.6363 is observed for B. licheniformis, B. subtilis, and G. stearothermophilus, respectively. The weak correlation for the latter is probably because of an observed time shift between pH and conductivity recording.
Figure 3.
Correlation curve for conductivity and pH.
To summarise the usefulness of the in-line sensor, one can conclude that out of the tested 6 correlations, 4 were close to or over 0.9, indicating a strong correlation between both permittivity-based VCD and optical density as well as pH and conductivity. The outstanding of G. stearothermophilus can be because of the different behaviour of its biosurfactant. It was reported that this strain produces a polymer-type biosurfactant instead, while the other two produce lipopeptide type biosurfactants [31].
3.2. Antifungal Assay
The data provided (Table 3.) are the findings of an antifungal experiment using the poisoned food technique to determine the impact of varying doses of B. licheniformis, B. subtilis, and G. stearothermophilus on the development of mycelium in a petri dish, i.e., in vitro.
Table 3.
Inhibition of A. alternata by B. licheniformis at 5% (A); 10% (B); 20% (C); and 30% (D); B. subtilis at 5% (E); 10% (F); 20% (G); and 30% (H); and G. stearothermophilus at 5% (I); 10% (J); 20% (K); and 30% (L); relative to the control (M).
Higher percentages indicate in Table 4. more suppression of mycelial development. The average growth of the control group was 89.68 ± 2.19 mm without any inhibition. The findings suggest that all three bacterial strains inhibited mycelial growth, with the most significant suppression (above 70%) reported at the highest dose tested (30%) for all Bacillus spp.—fermented broth.
Table 4.
In vitro inhibition of mycelial growth (%).
3.3. Disease Incidence and Severity
Fungal disease occurrence (Figure 4.) was significantly lower in the case of all three tested bacterial supernatants if applied before fungal infection. Post-infection treatments are inefficient since disease occurrences were similar to untreated but infected controls.
Figure 4.
Disease incidence of A. alternanta pre-infection treatment and post-infection treatment by Bacilli supernatants comparing mean significance with Tukey HSD. Small letters indicate the statistically different results groups.
However, Figure 5 depicts the impact of the three tested biosurfactants on the severity of the fungal infections, which is remarkably lower in the case of B. subtilis and B. licheniformis but is higher for G. stearothermophilus. At the same time, pre-infection treatment was observed to be more efficient than post-infection treatment. These indicate that emulsifying biosurfactants (polymeric type) are less effective against fungal infection than surface-tension-reducing (lipopeptide type).
Figure 5.
Disease severity of A. alternanta pre-treated and post-treated by biosurfactant comparing mean significance with Tukey HSD. Small letters indicate the statistically different results groups.
3.4. Chlorophyll Concentration
The decrement in chlorophyll contents (Figure 6.) indicates a decrease in the photosynthetic activities of the tested plants. The nontreated and non-infected control group contained one of the highest concentrations of chlorophyll a and b, suggesting that its photosynthetic activity is the highest. Similar chlorophyll contents were found only for bacilli-treated groups (BS-0, GS-0, BL-0), which indicates that these bacterial treatments are not harmful to bean plants. The statistical analysis reveals significant differences in chlorophyll levels across the groups, as shown by the values of Pr > F. (all less than 0.001). The lowest chlorophyll contents could be obtained in the post-infection treatment group, which confirms our above-described findings, i.e., pre-infection bacterial supernatant treatment is more efficient, resulting in 90% chlorophyll content of uninfected plants.
Figure 6.
Results of biosurfactant treatments and fungal infections on the chlorophyll content comparing mean significance with Tukey HSD of bean’s leaves: BS-A: pre-treatment with B. subtilis before A. alternata infection; GS-A: pre-treatment with B.subtilis before A. alternata infection; and BL-A: pre-treatment with B. licheniformis before A.alternata infection; A-BS, A-GS, and A-BL: pre-treatments with supernatant of B. subtilis, G. stearothermophilus, and B. licheniformis supernatant; uninfected but B. subtilis, G. stearothermophilus and B. licheniformis treated plants. Capital letters indicate the statistically different results groups.
3.5. Effect of Treatment and Infections on Plant Height
Figure 7 demonstrates that changes in total plant height, root length, and shoot length are not significant; thus, this method is not sensitive enough to indicate the fungal disease and its bacterial treatment. The ability of A. alternata to display both endophytic and pathogenic activity exemplifies this fungus’ adaptability and its ability to interact with a diverse array of host plants. This diversity may be attributable, in part, to the wide range of metabolites generated by A. alternata and the taxonomic group to which it belongs, which might support a variety of host interactions and nutritional strategies [32,33]. Somewhat higher lengths were obtained for B. subtilis treated but not infected plants. These might indicate that B. subtilis-based antifungal treatments may positively affect plant height, chlorophyll contents, disease severity and occurrences, and inhibition of fungal growth in vitro. While the Pr > F values are more than 0.05, statistical analysis reveals that none of the variations in plant height between the groups was statistically significant.
Figure 7.
Effect of different treatments on plant heights comparing mean significance with Tukey HSD. Capital letters indicate the statistically different results groups.
4. Discussion
The study explored the fermentation of biosurfactants by B. licheniformis and discovered a good correlation between the conductivity and primary fermentation products and between permittivity and the optical density of the fermentation broth. Such in-line real-time and continuous measurements support a better understanding of biosurfactant formation and reach higher productivity via cutting fermentations in optimal time [34,35]. The comparison of the tested three potential bio-fungicide-producing bacteria from fermentation revealed that the fastest cell growth could be reached by B. licheniformis with the highest biosurfactant amount resulting in the highest productivity. Compared to B. subtilis and G. stearothermophilus, B. licheniformis generated a larger output of biosurfactant throughout the fermentation process, with 15% and 5.2% more crude product, respectively. Compared to earlier research, which has reported yields ranging from 0.5 g/L to 1.8 g/L [3,36,37], the yield of the present study is relatively high. Our results indicate that our biosurfactant production method effectively achieved a high crude product yield.
The investigation into the potential of three bacterial strains to inhibiting the plant pathogenic fungus of A. alternata indicated that all of them were efficient under in vitro test conditions. However, in vivo plant experiments showed that the G. stearothermophylus broth supernatant was less successful in reducing disease incidence and severity. In contrast, the plants’ height and chlorophyll content were similar to the other bacterial treatments. On the other hand, it was discovered that B. subtilis and B. licheniformis were equally successful in treating the plants regarding severity and incidence. It is hypothesised that variations in bacterial biosurfactants may account for the different degrees of efficacy found in in vivo experiments. Including lipopeptide-type biosurfactants, such as lichenysin by B. licheniformis and surfactin by B. subtilis, in the broth resulted in comparable efficacy; however, polymeric-type emulsifying biosurfactants in the supernatant of G. stearothermophilus [31] resulted in a decreased efficacy.
The biosurfactant-producing bacteria B. subtilis, G. stearothermophilus, and B. licheniformis reduced the severity of A. alternata disease by up to 30%, 5%, and 25%, respectively, when applied to plants (i.e., in vivo). Additionally, the chlorophyll a and b concentrations of the bacterial supernatant-treated plants ranged from moderate to high, suggesting enhanced photosynthetic activity.
Overall, the research indicates that B. licheniformis is the most efficient bacterium for biosurfactant generation and biosurfactant treatment of plants. This work adds to the expanding body of knowledge on the use of biosurfactants for sustainable agriculture and indicates the potential for more research and development in this area.
5. Conclusions
The correlation coefficients between conductivity and pH and the association between permittivity and OD600 imply that these variables might be utilised to monitor biosurfactant production on a wide scale.
In conclusion, we can observe that lipopeptide-type biosurfactants are more effective bio fungicides than polymeric-type emulsifiers. The reason can be that air-mycelia and conidiospores (having somewhat hydrophobic behaviour) of plant pathogenic filamentous fungi can be better attacked if surface tension is controlled by biosurfactant-based bio fungicide in comparison to emulsification. The tested biosurfactant-producing bacilli, namely B. licheniformis and B. subtilis, are frequently used in biotechnology for different purposes, where the bacterial biomass is a discarded by-product. Our study highlighted the application of these cells as bio-fungicide, which can be a sustainable solution in the future.
Additionally, regarding in vivo plant treatments, increasing the sample size and replicating could help reduce the variability in the results and increase the study’s statistical power. Improved disease severity analyses using digital imagery and the connection between biosurfactant treatment and plant yield can be an interesting continuation.
Author Contributions
Methodology, J.J.S.; Resources, Á.N.; Writing—original draft, J.J.S.; Writing—review & editing, Á.N.; Supervision, Á.N. All authors have read and agreed to the published version of the manuscript.
Funding
This work was supported by the Stipendium Hungaricum Scholarship Programme Ph.D. grant: PhD Grant for Jesse John Sakiyo.
Data Availability Statement
The data presented in this study are available on request from the corresponding author.
Acknowledgments
Authors are grateful for MÉL Biotech K+F Ltd. for making possible the building of plant cultivation boxes as well as for data acquisition system for Hamilton Living Cell sensor.
Conflicts of Interest
The authors declare no conflict of interest.
References
- Markande, A.R.; Patel, D.; Varjani, S. A review on biosurfactants: Properties, applications and current developments. Bioresour. Technol. 2021, 330, 124963. [Google Scholar] [CrossRef]
- Bjerk, T.R.; Severino, P.; Jain, S.; Marques, C.; Silva, A.M.; Pashirova, T.; Souto, E.B. Biosurfactants: Properties and applications in drug delivery. Biotechnol. Ecotoxicol. Bioeng. 2021, 8, 115. [Google Scholar] [CrossRef]
- Joshi, S.J.; Al-Wahaibi, Y.M.; Al-Bahry, S.N.; Elshafie, A.E.; Al-Bemani, A.S.; Al-Bahri, A.; Al-Mandhari, M.S. Production, characterisation, and application of Bacillus licheniformis W16 Biosurfactant in enhancing oil recovery. Front. Microbiol. 2016, 7, 1853. [Google Scholar] [CrossRef]
- De Giani, A.; Zampolli, J.; Di Gennaro, P. Recent trends on biosurfactants with antimicrobial activity produced by bacteria associated with human health: Different perspectives on their properties, challenges, and potential applications. Front. Microbiol. 2021, 12, 655150. [Google Scholar] [CrossRef] [PubMed]
- Emmanuel ES, C.; Priya, S.S.; George, S. Isolation of biosurfactant from lactobacillus sp. and study of its inhibitory properties against e.coli biofilm. J. Pure Appl. Microbiol. 2019, 13, 403–411. [Google Scholar] [CrossRef]
- Hippolyte, M.T.; Augustin, M.; Hervé, T.M.; Robert, N.; Devappa, S. Application of response surface methodology to improve the production of antimicrobial biosurfactants by lactobacillus paracasei subsp. tolerans N2 using sugar cane molasses as substrate. Bioresour. Bioprocess. 2018, 5, 48. [Google Scholar] [CrossRef]
- Zhao, S.; Li, J.; Liu, J.; Xiao, S.; Yang, S.; Mei, J.; Ren, M.; Wu, S.; Zhang, H.; Yang, X. Secondary metabolites of Alternaria: A comprehensive review of chemical diversity and pharmacological properties. Front. Microbiol. 2023, 13. [Google Scholar] [CrossRef] [PubMed]
- Meena, M.; Samal, S. Alternaria host-specific (HSTs) toxins: An overview of chemical characterisation, target sites, regulation and their toxic effects. Toxicol. Rep. 2019, 6, 745–758. [Google Scholar] [CrossRef]
- Wang, J.-T.; Ma, Z.-H.; Wang, G.-K.; Xu, F.-Q.; Yu, Y.; Wang, G.; Peng, D.-Y.; Liu, J.-S. Chemical constituents from plant endophytic fungus Alternaria alternata. Nat. Prod. Res. 2019, 35, 1199–1206. [Google Scholar] [CrossRef]
- Chowdhary, A.; Agarwal, K.; Randhawa, H.S.; Kathuria, S.; Gaur, S.N.; Najafzadeh, M.J.; Roy, P.; Arora, N.; Khanna, G.; Meis, J.F. A rare case of allergic bronchopulmonary mycosis caused by Alternaria alternata. Med. Mycol. 2012, 50, 890–896. [Google Scholar] [CrossRef] [PubMed]
- Chandra, H.; Kumari, P.; Prasad, R.; Chandra Gupta, S.; Yadav, S. Antioxidant and antimicrobial activity displayed by a fungal endophyte Alternaria alternata isolated from Picrorhiza Kurroa from Garhwal Himalayas, India. Biocatal. Agric. Biotechnol. 2021, 33, 101955. [Google Scholar] [CrossRef]
- Singh, B.; Denning, D.W. Allergic bronchopulmonary mycosis due to Alternaria: Case report and review. Med. Mycol. Case Rep. 2012, 1, 20–23. [Google Scholar] [CrossRef]
- Kiss, B.; Németh, Á. Application of a high cell density capacitance sensor to different microorganisms. Period. Polytech. Chem. Eng. 2016, 60, 290–297. [Google Scholar] [CrossRef]
- Mitchell, D.A.; von Meien, O.F.; Krieger, N.; Dalsenter, F.D. A review of recent developments in modeling of microbial growth kinetics and intraparticle phenomena in solid-state fermentation. Biochem. Eng. J. 2004, 17, 15–26. [Google Scholar] [CrossRef]
- Kregiel, D.; Berlowska, J.; Szubzda, B. Novel permittivity test for determination of yeast surface charge and flocculation abilities. J. Ind. Microbiol. Biotechnol. 2012, 39, 1881–1886. [Google Scholar] [CrossRef]
- Gerzon, G.; Sheng, Y.; Kirkitadze, M. Process analytical technologies—Advances in Bioprocess Integration and future perspectives. J. Pharm. Biomed. Anal. 2022, 207, 114379. [Google Scholar] [CrossRef] [PubMed]
- Rathore, A.S. QBD/Pat for bioprocessing: Moving from theory to implementation. Curr. Opin. Chem. Eng. 2014, 6, 6. [Google Scholar] [CrossRef]
- Synkiewicz-Musialska, B.; Szwagierczak, D.; Kulawik, J.; Pałka, N.; Piasecki, P. Structural, thermal and dielectric properties of low dielectric permittivity cordierite-mullite-glass substrates at terahertz frequencies. Materials 2021, 14, 4030. [Google Scholar] [CrossRef]
- Mardanova, A.M.; Fanisovna Hadieva, G.; Tafkilevich Lutfullin, M.; Valer’evna Khilyas, I.; Farvazovna Minnullina, L.; Gadelevna Gilyazeva, A.; Mikhailovna Bogomolnaya, L.; Rashidovna Sharipova, M. Bacillus subtilis strains with antifungal activity against the phytopathogenic fungi. Agric. Sci. 2017, 8, 1–20. [Google Scholar] [CrossRef]
- Gomaa, E.Z. Antimicrobial activity of a biosurfactant produced by Bacillus licheniformis strain M104 grown on whey. Braz. Arch. Biol. Technol. 2013, 56, 259–268. [Google Scholar] [CrossRef]
- Kourmentza, K.; Gromada, X.; Michael, N.; Degraeve, C.; Vanier, G.; Ravallec, R.; Coutte, F.; Karatzas, K.A.; Jauregi, P. Antimicrobial activity of lipopeptide biosurfactants against foodborne pathogen and food spoilage microorganisms and their cytotoxicity. Front. Microbiol. 2021, 11, 561060. [Google Scholar] [CrossRef] [PubMed]
- Czinkóczky, R.; Sakiyo, J.; Eszterbauer, E.; Németh, Á. Prediction of surfactin fermentation with Bacillus subtilis DSM10 by response surface methodology optimised artificial neural network. Cell Biochem. Funct. 2023, 163, 107719. [Google Scholar] [CrossRef]
- Sakiyo, J.J.; Németh, Á. Optimisation of Bacillus licheniformis DSM13 for Biosurfactant production using response surface methodology. Hung. J. Ind. Chem. 2022, 50, 51–55. [Google Scholar] [CrossRef]
- Joshi, S.J.; Geetha, S.J.; Yadav, S.; Desai, A.J. Optimisation of bench-scale production of biosurfactant by Bacillus licheniformis R2. Apcbee Procedia 2013, 5, 232–236. [Google Scholar] [CrossRef]
- Joshi, S.; Bharucha, C.; Jha, S.; Yadav, S.; Nerurkar, A.; Desai, A.J. Biosurfactant production using molasses and whey under thermophilic conditions. Bioresour. Technol. 2008, 99, 195–199. [Google Scholar] [CrossRef]
- Czinkóczky, R.; Németh, Á. Techno-economic assessment of Bacillus fermentation to produce surfactin and lichenysin. Biochem. Eng. J. 2020, 163, 107719. [Google Scholar] [CrossRef]
- Kumar, S.N.; Nambisan, B.; Sundaresan, A.; Mohandas, C.; Anto, R.J. Isolation and identification of antimicrobial secondary metabolites from bacillus cereus associated with a rhabditid entomopathogenic nematode. Ann. Microbiol. 2013, 64, 209–218. [Google Scholar] [CrossRef]
- Gakuubi, M.M.; Maina, A.W.; Wagacha, J.M. Antifungal activity of essential oil of eucalyptus camaldulensis dehnh. against selected Fusarium spp. Int. J. Microbiol. 2017, 2017, 1–7. [Google Scholar] [CrossRef]
- Chiang, K.S.; Liu, H.I.; Bock, C.H. A discussion on disease severity index values. part I: Warning on inherent errors and suggestions to maximise accuracy. Ann. Appl. Biol. 2017, 171, 139–154. [Google Scholar] [CrossRef]
- Pérez-Patricio, M.; Camas-Anzueto, J.; Sanchez-Alegría, A.; Aguilar-González, A.; Gutiérrez-Miceli, F.; Escobar-Gómez, E.; Voisin, Y.; Rios-Rojas, C.; Grajales-Coutiño, R. Optical method for estimating the chlorophyll contents in plant leaves. Sensors 2018, 18, 650. [Google Scholar] [CrossRef]
- Czinkóczky, R.; Németh, A. Modeling the Biosurfactant Fermentation by Geobacillus stearothermophilus DSM2313. Period. Polytech. Chem. Eng. 2022, 67, 104–115. [Google Scholar] [CrossRef]
- DeMers, M. Alternaria alternata as endophyte and pathogen. Microbiology 2022, 168, 001153. [Google Scholar] [CrossRef] [PubMed]
- Delaye, L.; García-Guzmán, G.; Heil, M. Endophytes versus biotrophic and necrotrophic pathogens—Are fungal lifestyles evolutionarily stable traits? Fungal Div. 2013, 60, 125–135. [Google Scholar] [CrossRef]
- Rösner, L.; Walter, F.; Ude, C.; John, G.; Beutel, S. Sensors and techniques for on-line determination of cell viability in bioprocess monitoring. Bioengineering 2022, 9, 762. [Google Scholar] [CrossRef]
- Claßen, J.; Aupert, F.; Reardon, K.F.; Solle, D.; Scheper, T. Spectroscopic sensors for in-line bioprocess monitoring in research and Pharmaceutical Industrial Application. Anal. Bioanal. Chem. 2016, 409, 651–666. [Google Scholar] [CrossRef]
- El-Sheshtawy, H.S.; Aiad, I.; Osman, M.E.; Abo-ELnasr, A.A.; Kobisy, A.S. Production of biosurfactant from bacillus licheniformis for microbial enhanced oil recovery and inhibition the growth of sulfate reducing bacteria. Egypt. J. Pet. 2015, 24, 155–162. [Google Scholar] [CrossRef]
- Ali, N.; Wang, F.; Xu, B.; Safdar, B.; Ullah, A.; Naveed, M.; Wang, C.; Rashid, M.T. Production and application of biosurfactant produced by bacillus licheniformis ali5 in enhanced oil recovery and motor oil removal from contaminated sand. Molecules 2019, 24, 4448. [Google Scholar] [CrossRef]
Disclaimer/Publisher’s Note: The statements, opinions and data contained in all publications are solely those of the individual author(s) and contributor(s) and not of MDPI and/or the editor(s). MDPI and/or the editor(s) disclaim responsibility for any injury to people or property resulting from any ideas, methods, instructions or products referred to in the content. |
© 2023 by the authors. Licensee MDPI, Basel, Switzerland. This article is an open access article distributed under the terms and conditions of the Creative Commons Attribution (CC BY) license (https://creativecommons.org/licenses/by/4.0/).